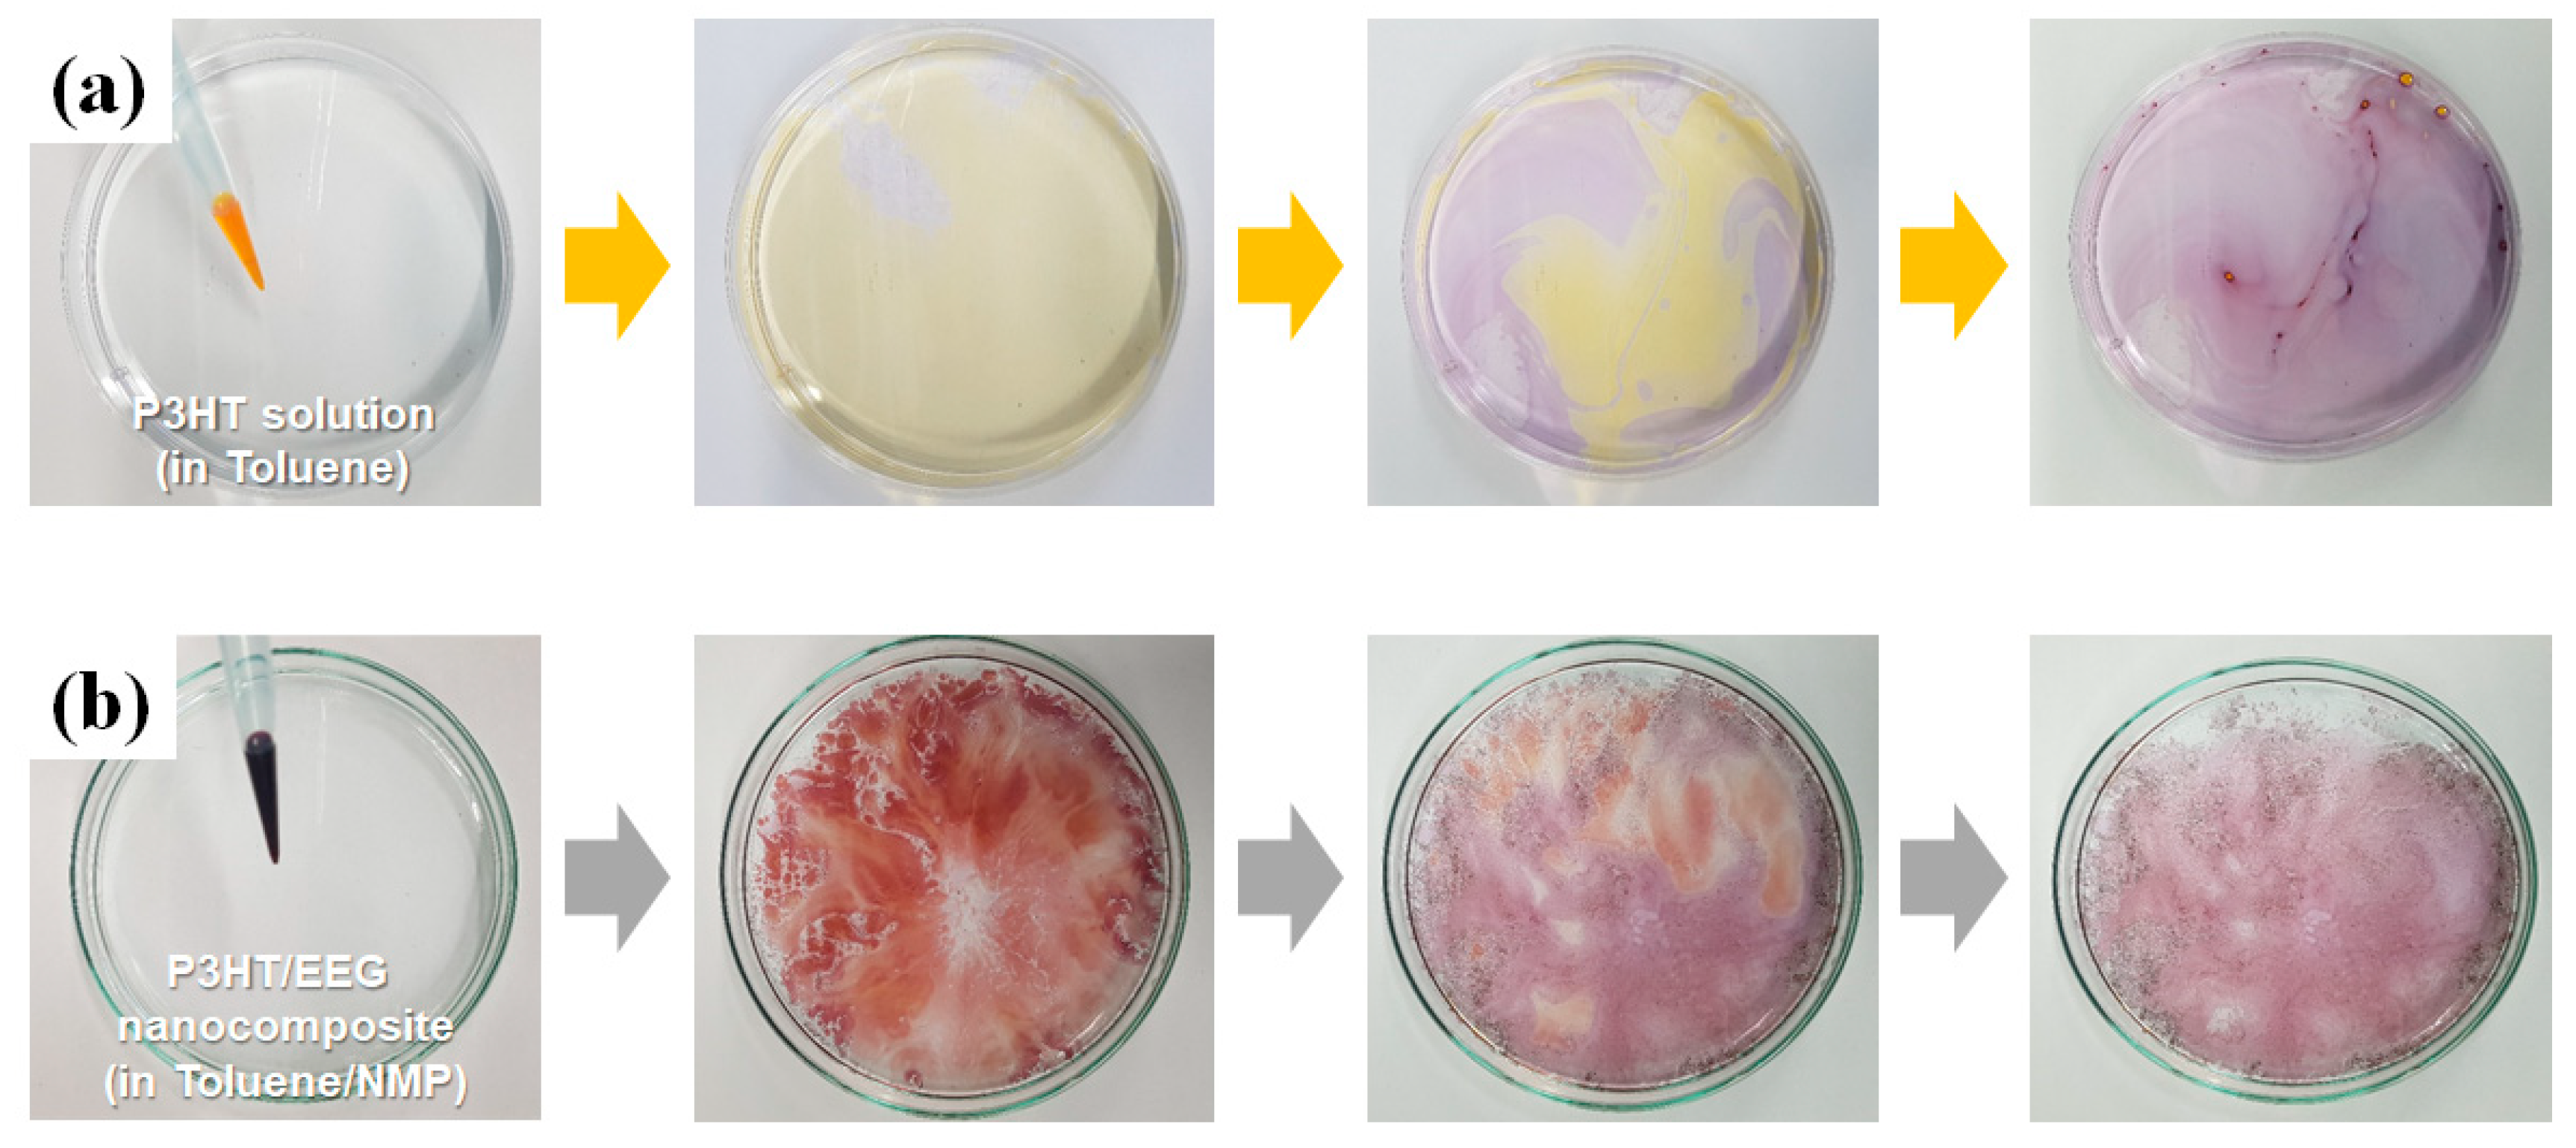
Polymers 12 01046 g002 Polymers 12 01046 g002

Preparation of Nanocomposite-Based High Performance Organic Field Effect Transistor via Solution Floating Method and Mechanical Property Evaluation
Abstract
1. Introduction
2. Materials and Methods
2.1. Materials
2.2. Solution-Floating Method for Fabrication of P3HT/EEG Nanocomposite Films
2.3. Fabrication of OFETs based on P3HT/EEG Nanocomposite Films
2.4. Measurements of Mechanical Properties of Nanocomposite Films (FOE Method)
2.5. Characterization
3. Results and Discussion
3.1. Preparation and Characterization of OFET based on the P3HT/EEG Nanocomposite Films via Solution Floating Method
3.2. Measurement of Mechanical Properties of P3HT/EEG Nanocomposite Films via Film-on-Elastomer Methods
4. Conclusions
Supplementary Materials
Author Contributions
Funding
Conflicts of Interest
References
- Coropceanu, V.; Cornil, J.; da Silva Filho, D.A.; Olivier, Y.; Silbey, R.; Brédas, J.-L. Charge transport in organic semiconductors. Chem. Rev. 2007, 107, 926–952. [Google Scholar] [CrossRef] [PubMed]
- Yang, H.; LeFevre, S.W.; Ryu, C.Y.; Bao, Z. Solubility-driven thin film structures of regioregular poly (3-hexyl thiophene) using volatile solvents. Appl. Phys. Lett. 2007, 90, 172116. [Google Scholar] [CrossRef]
- Oh, J.Y.; Shin, M.; Lee, T.I.; Jang, W.S.; Lee, Y.-J.; Kim, C.S.; Kang, J.-W.; Myoung, J.-M.; Baik, H.K.; Jeong, U. Highly bendable large-area printed bulk heterojunction film prepared by the self-seeded growth of poly (3-hexylthiophene) nanofibrils. Macromolecules 2013, 46, 3534–3543. [Google Scholar] [CrossRef]
- Lee, M.Y.; Hong, J.; Lee, E.K.; Yu, H.; Kim, H.; Lee, J.U.; Lee, W.; Oh, J.H. Highly flexible organic nanofiber phototransistors fabricated on a textile composite for wearable photosensors. Adv. Funct. Mater. 2016, 26, 1445–1453. [Google Scholar] [CrossRef]
- Wu, Y.; Liu, P.; Ong, B.S.; Srikumar, T.; Zhao, N.; Botton, G.; Zhu, S. Controlled orientation of liquid-crystalline polythiophene semiconductors for high-performance organic thin-film transistors. Appl. Phys. Lett. 2005, 86, 142102. [Google Scholar] [CrossRef]
- Lei, Y.; Deng, P.; Zhang, Q.; Xiong, Z.; Li, Q.; Mai, J.; Lu, X.; Zhu, X.; Ong, B.S. Hydrocarbons-driven crystallization of polymer semiconductors for low-temperature fabrication of high-performance organic field-effect transistors. Adv. Funct. Mater. 2018, 28, 1706372. [Google Scholar] [CrossRef]
- Wang, G.-J.N.; Molina-Lopez, F.; Zhang, H.; Xu, J.; Wu, H.-C.; Lopez, J.; Shaw, L.; Mun, J.; Zhang, Q.; Wang, S. Nonhalogenated solvent processable and printable high-performance polymer semiconductor enabled by isomeric nonconjugated flexible linkers. Macromolecules 2018, 51, 4976–4985. [Google Scholar] [CrossRef]
- Fan, X.; Wang, J.; Wang, H.; Liu, X.; Wang, H. Bendable ITO-free organic solar cells with highly conductive and flexible PEDOT: PSS electrodes on plastic substrates. ACS Appl. Mater. Interfaces 2015, 7, 16287–16295. [Google Scholar] [CrossRef]
- Lipomi, D.J.; Tee, B.C.K.; Vosgueritchian, M.; Bao, Z. Stretchable organic solar cells. Adv. Mater. 2011, 23, 1771–1775. [Google Scholar] [CrossRef]
- Kim, H.M.; Kang, H.W.; Hwang, D.K.; Lim, H.S.; Ju, B.K.; Lim, J.A. Metal–insulator–semiconductor coaxial microfibers based on self-organization of organic semiconductor: Polymer blend for weavable, fibriform organic field-effect transistors. Adv. Funct. Mater. 2016, 26, 2706–2714. [Google Scholar] [CrossRef]
- Kim, W.; Kwon, S.; Lee, S.-M.; Kim, J.Y.; Han, Y.; Kim, E.; Choi, K.C.; Park, S.; Park, B.-C. Soft fabric-based flexible organic light-emitting diodes. Org. Electron. 2013, 14, 3007–3013. [Google Scholar] [CrossRef]
- Song, M.; Seo, J.; Kim, H.; Kim, Y. Flexible thermal sensors based on organic field-effect transistors with polymeric channel/gate-insulating and light-blocking layers. ACS Omega 2017, 2, 4065–4070. [Google Scholar] [CrossRef] [PubMed]
- Reese, C.; Roberts, M.; Ling, M.-M.; Bao, Z. Organic thin film transistors. Mater. Today 2004, 7, 20–27. [Google Scholar] [CrossRef]
- Ling, H.; Liu, S.; Zheng, Z.; Yan, F. Organic flexible electronics. Small Methods 2018, 2, 1800070. [Google Scholar] [CrossRef]
- Lim, B.; Long, D.X.; Han, S.-Y.; Nah, Y.-C.; Noh, Y.-Y. Well-defined alternative polymer semiconductor using large size regioregular building blocks as monomers: Electrical and electrochemical properties. J. Mater. Chem. C 2018, 6, 5662–5670. [Google Scholar] [CrossRef]
- Lee, J.; Kang, S.H.; Lee, S.M.; Lee, K.C.; Yang, H.; Cho, Y.; Han, D.; Li, Y.; Lee, B.H.; Yang, C. An ultrahigh mobility in isomorphic fluorobenzo [c][1, 2, 5] thiadiazole-based polymers. Angew. Chem. 2018, 130, 13817–13822. [Google Scholar] [CrossRef]
- Liu, S.; Mannsfeld, S.C.; LeMieux, M.C.; Lee, H.W.; Bao, Z. Organic semiconductor-carbon nanotube bundle bilayer field effect transistors with enhanced mobilities and high on/off ratios. Appl. Phys. Lett. 2008, 92, 34. [Google Scholar] [CrossRef]
- Novoselov, K.S.; Geim, A.K.; Morozov, S.; Jiang, D.; Katsnelson, M.I.; Grigorieva, I.; Dubonos, S.; Firsov, A.A. Two-dimensional gas of massless Dirac fermions in graphene. Nature 2005, 438, 197–200. [Google Scholar] [CrossRef]
- Park, S.; Ruoff, R.S. Chemical methods for the production of graphenes. Nat. Nanotechnol. 2009, 4, 217. [Google Scholar] [CrossRef]
- Geng, J.; Kong, B.S.; Yang, S.B.; Youn, S.C.; Park, S.; Joo, T.; Jung, H.T. Effect of SWNT defects on the electron transfer properties in P3HT/SWNT hybrid materials. Adv. Funct. Mater. 2008, 18, 2659–2665. [Google Scholar] [CrossRef]
- Huang, J.; Hines, D.R.; Jung, B.J.; Bronsgeest, M.S.; Tunnell, A.; Ballarotto, V.; Katz, H.E.; Fuhrer, M.S.; Williams, E.D.; Cumings, J. Polymeric semiconductor/graphene hybrid field-effect transistors. Org. Electron. 2011, 12, 1471–1476. [Google Scholar] [CrossRef]
- Yoon, K.H.; Lee, Y.S. Effects of multi-walled carbon nanotube and flow types on the electrical conductivity of polycarbonate/carbon nanotube nanocomposites. Carbon Lett. 2019, 29, 57–63. [Google Scholar]
- Gnidakouong, J.R.N.; Gao, X.; Kafy, A.; Kim, J.; Kim, J.-H. Fabrication and electrical properties of regenerated cellulose-loaded exfoliated graphene nanoplatelet composites. Carbon Lett. 2019, 29, 115–122. [Google Scholar]
- Kwon, Y.J.; Kwon, Y.; Park, H.S.; Lee, J.U. Mass-produced electrochemically exfoliated graphene for ultrahigh thermally conductive paper using a multimetal electrode system. Adv. Mater. Interfaces 2019, 6, 1900095. [Google Scholar] [CrossRef]
- Vu, D.-L.; Kwon, Y.J.; Lee, S.C.; Lee, J.U.; Lee, J.-W. Exfoliated graphene nanosheets as high-power anodes for lithium-ion batteries. Carbon Lett. 2019, 29, 81–87. [Google Scholar]
- Kim, Y.-J.; Park, K.; Jung, H.-T.; Ahn, C.W.; Jeon, H.-J. Effects of solution annealing on the crystallinity and growth of conjugated polymer nanowires on a water substrate. Cryst. Growth Des. 2018, 18, 1261–1266. [Google Scholar] [CrossRef]
- Kim, Y.J.; Jung, H.T.; Ahn, C.W.; Jeon, H.J. Simultaneously induced self-assembly of poly (3-hexylthiophene)(P3HT) nanowires and thin-film fabrication via solution-floating method on a water substrate. Adv. Mater. Interfaces 2017, 4, 1700342. [Google Scholar] [CrossRef]
- Sirringhaus, H.; Tessler, N.; Friend, R.H. Integrated optoelectronic devices based on conjugated polymers. Science 1998, 280, 1741–1744. [Google Scholar] [CrossRef]
- McCulloch, I.; Heeney, M.; Bailey, C.; Genevicius, K.; MacDonald, I.; Shkunov, M.; Sparrowe, D.; Tierney, S.; Wagner, R.; Zhang, W. Liquid-crystalline semiconducting polymers with high charge-carrier mobility. Nat. Mater. 2006, 5, 328–333. [Google Scholar] [CrossRef]
- Savagatrup, S.; Makaram, A.S.; Burke, D.J.; Lipomi, D.J. Mechanical properties of conjugated polymers and polymer-fullerene composites as a function of molecular structure. Adv. Funct. Mater. 2014, 24, 1169–1181. [Google Scholar] [CrossRef]
- Chung, J.Y.; Nolte, A.J.; Stafford, C.M. Surface wrinkling: A versatile platform for measuring thin-film properties. Adv. Mater. 2011, 23, 349–368. [Google Scholar] [CrossRef] [PubMed]
- Park, M.; Park, J.-S.; Han, I.K.; Oh, J.Y. High-performance flexible and air-stable perovskite solar cells with a large active area based on poly (3-hexylthiophene) nanofibrils. J. Mater. Chem. A 2016, 4, 11307–11316. [Google Scholar] [CrossRef]
- Georgakilas, V.; Otyepka, M.; Bourlinos, A.B.; Chandra, V.; Kim, N.; Kemp, K.C.; Hobza, P.; Zboril, R.; Kim, K.S. Functionalization of graphene: Covalent and non-covalent approaches, derivatives and applications. Chem. Rev. 2012, 112, 6156–6214. [Google Scholar] [CrossRef] [PubMed]
- Dreyer, D.R.; Park, S.; Bielawski, C.W.; Ruoff, R.S. The chemistry of graphene oxide. Chem. Soc. Rev. 2010, 39, 228–240. [Google Scholar] [CrossRef] [PubMed]
- Tiwari, S.; Singh, A.K.; Prakash, R. Poly (3-hexylthiophene)(P3HT)/graphene nanocomposite material based organic field effect transistor with enhanced mobility. J. Nanosci. Nanotechnol. 2014, 14, 2823–2828. [Google Scholar] [CrossRef]
- Yadav, A.; Upadhyaya, A.; Gupta, S.K.; Verma, A.S.; Negi, C.M.S. Poly-(3-hexylthiophene)/graphene composite based organic photodetectors: The influence of graphene insertion. Thin Solid Film. 2019, 675, 128–135. [Google Scholar] [CrossRef]
- Zheng, F.; Yang, X.-Y.; Bi, P.-Q.; Niu, M.-S.; Lv, C.-K.; Feng, L.; Qin, W.; Wang, Y.-Z.; Hao, X.-T.; Ghiggino, K.P. Poly (3-hexylthiophene) coated graphene oxide for improved performance of bulk heterojunction polymer solar cells. Org. Electron. 2017, 44, 149–158. [Google Scholar] [CrossRef]
- Rodriquez, D.; Kim, J.-H.; Root, S.E.; Fei, Z.; Boufflet, P.; Heeney, M.; Kim, T.-S.; Lipomi, D.J. Comparison of methods for determining the mechanical properties of semiconducting polymer films for stretchable electronics. ACS Appl. Mater. Interfaces 2017, 9, 8855–8862. [Google Scholar] [CrossRef]
- Pandey, R.K.; Sahu, P.K.; Singh, M.K.; Prakash, R. Fast grown self-assembled polythiophene/graphene oxide nanocomposite thin films at air–liquid interface with high mobility used in polymer thin film transistors. J. Mater. Chem. C 2018, 6, 9981–9989. [Google Scholar]
- Chen, Y.-H.; Huang, P.-T.; Lin, K.-C.; Huang, Y.-J.; Chen, C.-T. Stabilization of poly (3-hexylthiophene)/PCBM morphology by hydroxyl group end-functionalized P3HT and its application to polymer solar cells. Org. Electron. 2012, 13, 283–289. [Google Scholar] [CrossRef]
- Aïssa, B.; Nedil, M.; Kroeger, J.; Ali, A.; Isaifan, R.J.; Essehli, R.; Mahmoud, K.A. Graphene nanoplatelet doping of P3HT: PCBM photoactive layer of bulk heterojunction organic solar cells for enhancing performance. Nanotechnology 2018, 29, 105405. [Google Scholar] [CrossRef] [PubMed]
- Rodriquez, D.; Savagatrup, S.; Valle, E.; Proctor, C.M.; McDowell, C.; Bazan, G.C.; Nguyen, T.-Q.; Lipomi, D.J. Mechanical properties of solution-processed small-molecule semiconductor films. ACS Appl. Mater. Interfaces 2016, 8, 11649–11657. [Google Scholar] [CrossRef] [PubMed]
- Liscio, A.; Veronese, G.P.; Treossi, E.; Suriano, F.; Rossella, F.; Bellani, V.; Rizzoli, R.; Samorì, P.; Palermo, V. Charge transport in graphene–polythiophene blends as studied by Kelvin Probe Force Microscopy and transistor characterization. J. Mater. Chem. 2011, 21, 2924–2931. [Google Scholar] [CrossRef]
- Root, S.E.; Savagatrup, S.; Printz, A.D.; Rodriquez, D.; Lipomi, D.J. Mechanical properties of organic semiconductors for stretchable, highly flexible, and mechanically robust electronics. Chem. Rev. 2017, 117, 6467–6499. [Google Scholar] [CrossRef]
- Stafford, C.M.; Harrison, C.; Beers, K.L.; Karim, A.; Amis, E.J.; VanLandingham, M.R.; Kim, H.-C.; Volksen, W.; Miller, R.D.; Simonyi, E.E. A buckling-based metrology for measuring the elastic moduli of polymeric thin films. Nat. Mater. 2004, 3, 545–550. [Google Scholar] [CrossRef]
- Bowden, N.; Brittain, S.; Evans, A.G.; Hutchinson, J.W.; Whitesides, G.M. Spontaneous formation of ordered structures in thin films of metals supported on an elastomeric polymer. Nature 1998, 393, 146–149. [Google Scholar] [CrossRef]
- Bowden, N.; Huck, W.T.; Paul, K.E.; Whitesides, G.M. The controlled formation of ordered, sinusoidal structures by plasma oxidation of an elastomeric polymer. Appl. Phys. Lett. 1999, 75, 2557–2559. [Google Scholar] [CrossRef]
- Tahk, D.; Lee, H.H.; Khang, D.-Y. Elastic moduli of organic electronic materials by the buckling method. Macromolecules 2009, 42, 7079–7083. [Google Scholar] [CrossRef]
- Lipomi, D.J.; Chong, H.; Vosgueritchian, M.; Mei, J.; Bao, Z. Toward mechanically robust and intrinsically stretchable organic solar cells: Evolution of photovoltaic properties with tensile strain. Sol. Energy Mater. Sol. Cells 2012, 107, 355–365. [Google Scholar] [CrossRef]
- Park, S.I.; Ahn, J.H.; Feng, X.; Wang, S.; Huang, Y.; Rogers, J.A. Theoretical and experimental studies of bending of inorganic electronic materials on plastic substrates. Adv. Funct. Mater. 2008, 18, 2673–2684. [Google Scholar] [CrossRef]
- O‘Connor, T.F.; Zaretski, A.V.; Shiravi, B.A.; Savagatrup, S.; Printz, A.D.; Diaz, M.I.; Lipomi, D.J. Stretching and conformal bonding of organic solar cells to hemispherical surfaces. Energy Environ. Sci. 2014, 7, 370–378. [Google Scholar] [CrossRef]
- Kim, T.; Kim, J.-H.; Kang, T.E.; Lee, C.; Kang, H.; Shin, M.; Wang, C.; Ma, B.; Jeong, U.; Kim, T.-S. Flexible, highly efficient all-polymer solar cells. Nat. Commun. 2015, 6, 1–7. [Google Scholar] [CrossRef] [PubMed]

| Parameters | Pristine P3HT | P3HT/EEG2.5 | P3HT/EEG5 | P3HT/EEG10 | P3HT/EEG20 |
|---|---|---|---|---|---|
| μFET (cm2·V−1·s−1) | 0.0227 | 0.0223 | 0.0278 | 0.0391 | − |
| Ion/Ioff | ~103 | ~103 | ~104 | ~104 | − |
| VTh (V) | −6.97 | −8.87 | −11.8 | −15.8 | − |
© 2020 by the authors. Licensee MDPI, Basel, Switzerland. This article is an open access article distributed under the terms and conditions of the Creative Commons Attribution (CC BY) license (http://creativecommons.org/licenses/by/4.0/).
Share and Cite
Kim, Y.; Kwon, Y.J.; Ryu, S.; Lee, C.J.; Lee, J.U. Preparation of Nanocomposite-Based High Performance Organic Field Effect Transistor via Solution Floating Method and Mechanical Property Evaluation. Polymers 2020, 12, 1046. https://doi.org/10.3390/polym12051046
Kim Y, Kwon YJ, Ryu S, Lee CJ, Lee JU. Preparation of Nanocomposite-Based High Performance Organic Field Effect Transistor via Solution Floating Method and Mechanical Property Evaluation. Polymers. 2020; 12(5):1046. https://doi.org/10.3390/polym12051046
Chicago/Turabian StyleKim, Youn, Yeon Ju Kwon, Seungwan Ryu, Cheol Jin Lee, and Jea Uk Lee. 2020. "Preparation of Nanocomposite-Based High Performance Organic Field Effect Transistor via Solution Floating Method and Mechanical Property Evaluation" Polymers 12, no. 5: 1046. https://doi.org/10.3390/polym12051046
APA StyleKim, Y., Kwon, Y. J., Ryu, S., Lee, C. J., & Lee, J. U. (2020). Preparation of Nanocomposite-Based High Performance Organic Field Effect Transistor via Solution Floating Method and Mechanical Property Evaluation. Polymers, 12(5), 1046. https://doi.org/10.3390/polym12051046
